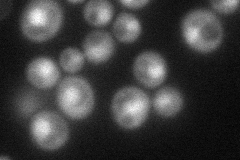
YNL092W
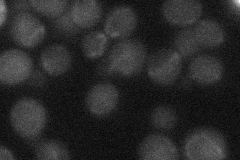
YNL092W
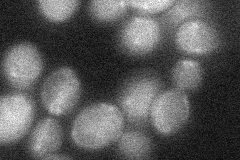
YNL092W
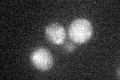
YNL092W

View description
Putative S-adenosylmethionine-dependent methyltransferase of the seven beta-strand family; YNL092W is not an essential gene
Localization:
Intensity:
Fold change:
Significance:
-
C’ GFP library in SD

below threshold16.5 -
N' NOP1pr-GFP in SD
cytosol,nucleus67.9667 -
N' TEF2pr-mCherry in SD

nucleus48.0325 -
N' NATIVEpr-GFP in SD
below threshold23.174 -
N' TEF2pr-VC and Cyto-VN in SD
below threshold26.6855 -
C’ GFP library in SD+DTT

cytosol17.61.06No -
C’ GFP library in SD+H2O2
cytosol19.491.18No -
C’ GFP library in Starvation Media

cytosol31.641.91No -
C’ GFP library on the background of Pup2-DaMP

below threshold -
C’ GFP library on the background of CCT mutant

below threshold16.45010.996587No
